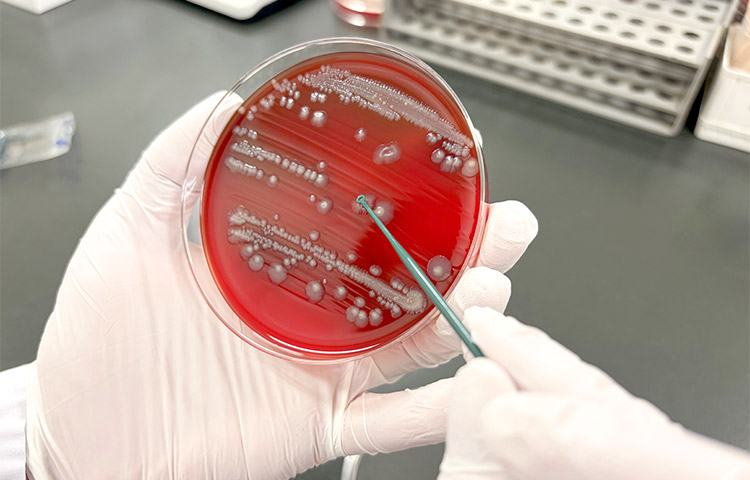

検査課

職場概要
2026年4月現在、検査課には臨床検査技師37名(男性6名、女性31名)および採血要員として看護師1名が在籍しております。
主な業務として、血液検査、生化学・免疫検査、一般検査、輸血検査、細菌検査などの検体検査と、超音波検査、心電図検査、脳波検査、肺活量検査、聴力検査などの生理検査、そして外来採血を実施しており、日曜・祝日は日直体制、夜間は当直体制にて24時間診療を支えています。
また、隣接する健診センターの業務にも携わり、急性期医療から予防医療まで幅広く貢献しています。
さらに、チーム医療の一員としての役割を重視し、NST(栄養サポートチーム)や褥瘡対策、ICT(感染対策チーム)などのラウンドにも積極的に参加するとともに、手術中の迅速病理診断にも参画し、安全で質の高い医療の提供に貢献しています。
その他、検査品質の維持・向上を目的として、課内に複数の委員会を設置し、業務改善や精度管理、教育体制の充実に継続的に取り組んでいます。加えて、スタッフは各種学会や勉強会への参加、認定資格の取得にも積極的に取り組み、専門性の向上に努めています。
主な業務として、血液検査、生化学・免疫検査、一般検査、輸血検査、細菌検査などの検体検査と、超音波検査、心電図検査、脳波検査、肺活量検査、聴力検査などの生理検査、そして外来採血を実施しており、日曜・祝日は日直体制、夜間は当直体制にて24時間診療を支えています。
また、隣接する健診センターの業務にも携わり、急性期医療から予防医療まで幅広く貢献しています。
さらに、チーム医療の一員としての役割を重視し、NST(栄養サポートチーム)や褥瘡対策、ICT(感染対策チーム)などのラウンドにも積極的に参加するとともに、手術中の迅速病理診断にも参画し、安全で質の高い医療の提供に貢献しています。
その他、検査品質の維持・向上を目的として、課内に複数の委員会を設置し、業務改善や精度管理、教育体制の充実に継続的に取り組んでいます。加えて、スタッフは各種学会や勉強会への参加、認定資格の取得にも積極的に取り組み、専門性の向上に努めています。
臨床検査技師とは
臨床検査技師は、医師の診断や治療方針の決定に欠かすことのできない「検査」を専門に担う医療職です。
血液や尿などの検体を調べる検体検査や、心電図や超音波検査など、患者さんの体を直接調べる生理検査を通して、病気の早期発見や治療効果の評価に貢献しています。
我々が扱う検査結果は、診断や治療に直結する重要な医療情報です。そのため、正確性はもちろん、迅速性も強く求められる責任ある仕事です。
臨床検査技師には、高度な専門知識と確かな技術が必要とされますが、その分、専門分野を深めたり、認定資格を取得したりと、自分の興味や目標に合わせて成長できる環境があります。医療の進歩とともに活躍の場が広がっている点も、この職業の大きな魅力です。
「医療に関わりたい」「人の役に立ちたい」「専門性を身につけたい」そんな思いを持つ方にとって、臨床検査技師はやりがいと可能性にあふれた医療職です。
血液や尿などの検体を調べる検体検査や、心電図や超音波検査など、患者さんの体を直接調べる生理検査を通して、病気の早期発見や治療効果の評価に貢献しています。
我々が扱う検査結果は、診断や治療に直結する重要な医療情報です。そのため、正確性はもちろん、迅速性も強く求められる責任ある仕事です。
臨床検査技師には、高度な専門知識と確かな技術が必要とされますが、その分、専門分野を深めたり、認定資格を取得したりと、自分の興味や目標に合わせて成長できる環境があります。医療の進歩とともに活躍の場が広がっている点も、この職業の大きな魅力です。
「医療に関わりたい」「人の役に立ちたい」「専門性を身につけたい」そんな思いを持つ方にとって、臨床検査技師はやりがいと可能性にあふれた医療職です。
職場理念
聖隷検査部門 理念
私たちは高い専門性を追求し、以って利用者視点に立った医療人を目指し、
臨床検査を通して地域社会に貢献します。
行動指針
-
専門性を高め、新しいことにチャレンジします。
-
精度と迅速性を追求した臨床検査情報を提供します。
-
知識・技術を常に高め、地域医療に貢献します。
-
医療人として広い視野を持ち、バランスのとれた行動思考を持つ人材を育成します。
-
医療情勢を知り変化に迅速に対応します。
-
多職種と協働しチーム医療に貢献します。
業務紹介
検体検査
生化学検査
生化学検査では、血清中や血漿中の様々な成分を、自動分析機を用いて分析しています。
健康診断の結果でよく目にするγ-GTや血糖値などを分析する検査です。
肝機能・腎機能・脂質異常・糖代謝・炎症反応などを評価するのに欠かせない検査です。
健康診断の結果でよく目にするγ-GTや血糖値などを分析する検査です。
肝機能・腎機能・脂質異常・糖代謝・炎症反応などを評価するのに欠かせない検査です。
免疫検査
免疫検査では、血清または血漿を用いてB型肝炎・C型肝炎等の感染症検査やPSA・CEA 等の腫瘍マーカーを分析しています。

 (4).jpg)
自動分析機を用いた生化学・免疫検査
血液検査
血液検査では、血液中の白血球や赤血球を計測したり、血液細胞を顕微鏡で観察したりして、貧血や感染症、血液疾患などの異常がないかを調べています。また、血液がどのように固まるかを調べる凝固検査を行っています。

多項目自動血球分析装置

血液細胞の鏡検
一般検査
一般検査では、尿定性検査や尿沈渣検査により尿路感染症や悪性細胞の有無などを調べています。また、髄液や関節液、胸水などの性状を調べる体腔液検査、顕微鏡を用いて白癬菌や虫卵の有無を調べる鏡検検査などを行っています。
2.jpg)

全自動尿分析装置
輸血検査
輸血検査では、貧血や出血、手術時などで輸血が必要になった場合、患者さんに必要な血液成分を補充する輸血に関わる検査全般を行っています。
主な検査は血液型検査・不規則性抗体検査・交差適合試験などです。
全自動輸血検査装置での検査に加え、症例に応じて、用手法にて精査も行っています。
また、輸血に必要な血液製剤の保管・在庫管理・出庫業務を24時間体制で行い、安全な輸血の提供に努めています。
主な検査は血液型検査・不規則性抗体検査・交差適合試験などです。
全自動輸血検査装置での検査に加え、症例に応じて、用手法にて精査も行っています。
また、輸血に必要な血液製剤の保管・在庫管理・出庫業務を24時間体制で行い、安全な輸血の提供に努めています。

全自動輸血検査装置

用手法にて精査
細菌検査
細菌検査では、喀痰・尿・便・血液・膿などの検体から培養、同定検査によって起因微生物を検出し、薬剤感受性検査によってどの薬が効くのかを調べています。またコロナウイルスをはじめとする様々なウイルス抗原検査や、抗酸菌などの病原体核酸検査を行っています。
培養、同定検査

微生物同定感受性分析装置
生理検査
生理検査は、様々な検査機器を用いて、患者様の身体の状態や機能を直接検査します。検査室の中で最も患者様と接することが多い部門です。患者さんが安全に安心して検査を受けることが出来るように日々心がけています。
主な検査項目
| 循環生理 | 心電図・負荷心電図(マスター・トレッドミル)・ホルター心電図・ABI |
|---|---|
| 呼吸機能 | 肺活量(VC・FVC)・気道可逆試験 |
| 神経生理 | 脳波・神経伝導速度・聴性脳幹反応 |
| 聴力機能 | 標準純音聴力・標準語音聴力・ティンパノメトリー・耳小骨筋反射 |
| 超音波 | 心臓・頸動脈・下肢静脈 |
.jpg)
心臓超音波検査

トレッドミル検査
術中迅速病理検査
手術中に採取した組織を「がんか良性か」「リンパ節転移があるか」などを短時間で診断する検査です。手術の範囲や方法を決定するために重要な検査で、確実な切除と過剰な切除の回避、再手術の減少に貢献しています。(当院では聖隷浜松病院に依頼し、遠隔医療のひとつ「テレパソロジー」を実施しています。)


外来採血
外来採血室では、朝8時15分より外来患者様の採血・採尿・検体採取などを行っています。朝の混雑時は3名で対応し、1日約150名程度の採血をしています。本人確認を徹底し、安全な採血が出来るよう心がけています。

健診業務
病院だけではなく、隣接する健診センターにて、身体計測・採血・心電図検査・聴力検査・眼底検査・肺活量検査・超音波検査・動脈硬化検査を行っています。

採血
.jpg)
動脈硬化検査
.jpg)
エコー検査(腹部)
また、検診車で事業所に出向き、心電図検査・腹囲測定・聴力検査・超音波検査・眼底検査・VDT検査なども行っています。

施設認定状況
品質保証施設認証 取得(認証期間 2025年6月1日~2027年5月31日)

同認証は臨床検査の品質と安全性を、組織的・継続的に確保している施設であることを、日本臨床衛生検査技師会が第三者的に認証する制度で、臨床検査の「正確性」「信頼性」「再現性」を、人・設備・体制・運用の面から総合的に評価します。当院では院内で検査を実施している臨床化学、血液、一般、免疫、微生物、輸血、生理の6部門すべてに関して認証を取得しました。
外部精度管理状況
- 日本医師会臨床検査精度管理調査
- 日臨技臨床検査精度管理調査
- 静岡県臨床検査精度管理調査
- 全国労働衛生団体連合会 臨床検査精度管理調査・腹部超音波検査精度管理調査
- 日本超音波検査学会 画像コントロールサーベイ
認定資格者状況
2026年4月時点
| 主催 | 認定資格 | 取得者数 |
|---|---|---|
| 日本臨床衛生検査技師会 | 認定一般検査技師 | 1名 |
| 認定救急検査技師 | 1名 | |
| 日本臨床検査同学院 | 二級臨床検査士(血液学) | 2名 |
| 二級臨床検査士(微生物学) | 2名 | |
| 二級臨床検査士(病理学) | 1名 | |
| 緊急臨床検査士 | 8名 | |
| 遺伝子分析科学認定士(初級) | 1名 | |
| 日本輸血・細胞治療学会 | 認定輸血検査技師 | 1名 |
| 日本臨床細胞学会 | 細胞検査士 | 1名 |
| 日本超音波医学会 | 超音波検査士(消化器領域) | 10名 |
| 超音波検査士(泌尿器領域) | 8名 | |
| 超音波検査士(体表臓器領域) | 6名 | |
| 超音波検査士(循環器領域) | 3名 | |
| 超音波検査士(健診領域) | 3名 | |
| 日本乳がん検診精度管理中央機構 | 乳房超音波検査講習会認定 | 7名 |
| NPO法人乳房健康研究会 | ピンクリボンアドバイザー(初級) | 1名 |
| 日本臨床神経生理学会 | 専門技術師(脳波分野) | 1名 |
| 日本不整脈心電学会 | JHRS認定心電図専門士 | 1名 |
| 心電図検定1級 | 1名 | |
| 心電図検定2級 | 8名 | |
| 心電図検定3級 | 8名 | |
| 厚生労働省 | 肝炎医療コーディネーター | 2名 |
教育体制
当検査課では、「目標管理システム」を用い、「キャリアラダー」ツールを使ってOJT(職場内研修)やOffJT(各種学会や研修)を組み合わせ、スタッフの人材育成に取り組んでいます。
検査技術能力・組織管理能力・教育管理能力を育成する為、検査課内で教育管理委員会を発足し、各種勉強会の計画やラダー進捗状況及び実績の管理を行っています。
また、「目標参画シート」及び「キャリアラダー能力評価表」を用い、年度ごとにスタッフ全員、職場目標に対して自分にできることは何か?己のレベルアップをするためにはどうすればよいか?等を考え、それぞれのレベルにあった個人目標を作成し、目標達成にむけて活動していきます。そして、PDCAサイクルを基に、年3回(初回・中間・最終)の面接を役職者とおこないます。
初回面接では、スタッフがたてた目標やそれに対する具体的方法の適正さや計画性を検討します。中間面接では、目標計画の進捗状況を確認し、計画や目標自体に修正が必要となった場合は、この時点で修正をおこないます。最終面接では、目標の達成状況を確認し、未達成な目標に関しては、なぜ達成できなかったのかを考え、次のステップへと繋げていきます。
検査技術能力・組織管理能力・教育管理能力を育成する為、検査課内で教育管理委員会を発足し、各種勉強会の計画やラダー進捗状況及び実績の管理を行っています。
また、「目標参画シート」及び「キャリアラダー能力評価表」を用い、年度ごとにスタッフ全員、職場目標に対して自分にできることは何か?己のレベルアップをするためにはどうすればよいか?等を考え、それぞれのレベルにあった個人目標を作成し、目標達成にむけて活動していきます。そして、PDCAサイクルを基に、年3回(初回・中間・最終)の面接を役職者とおこないます。
初回面接では、スタッフがたてた目標やそれに対する具体的方法の適正さや計画性を検討します。中間面接では、目標計画の進捗状況を確認し、計画や目標自体に修正が必要となった場合は、この時点で修正をおこないます。最終面接では、目標の達成状況を確認し、未達成な目標に関しては、なぜ達成できなかったのかを考え、次のステップへと繋げていきます。
先輩の声
検査課 臨床検査技師(2024年入職)

Q1. 聖隷沼津病院・健診センターに入職の動機・きっかけ・決め手は?
自分が生まれ育った地域である沼津市の医療に携わりたいと思ったからです。
Q2. 職場の雰囲気を教えてください。
先輩方は丁寧に業務を教えてくれて、相談もしやすい職場だと思います。
Q3. あなたのお仕事内容を教えてください。
一般検査、血液検査を担当しています。
また、外部健診にて心電図や聴力検査の業務も行っています。
また、外部健診にて心電図や聴力検査の業務も行っています。
Q4. やりがいを感じる瞬間は?
私が行っている検体分析の仕事は患者さんと直接関わる機会は少ないですが、
測定した結果を正しく返すことで患者さんの健康を守ることに繋がっていると思うと、
やりがいのある仕事だなと思います。
測定した結果を正しく返すことで患者さんの健康を守ることに繋がっていると思うと、
やりがいのある仕事だなと思います。
Q5. 休暇は取れていますか?取りやすい環境ですか?
休暇は取りやすい環境だと思います。希望はきちんと聞いてもらえます。
Q6. 研究や自己研鑽は何かしていますか?また職場の協力体制はありますか?
心電図検定3級を受験する予定です。
また、各種勉強会やセミナーに参加することで自己研鑽を行っています。
また、各種勉強会やセミナーに参加することで自己研鑽を行っています。
Q7. 教育体制はどうですか?充実していますか?
チェックシートを用い、新人教育を進めていく形です。
疑問点があればすぐに相談できる環境です。当直の練習も丁寧に行ってもらえます。
疑問点があればすぐに相談できる環境です。当直の練習も丁寧に行ってもらえます。
Q8. プライベートの過ごし方は?ワークライフバランスのコツはなんですか?
休みの日は家族や友達とおいしいものを食べに行ったり、ゆっくり体を休めたりしています。
仕事中と休日のメリハリをつけて過ごしています。
仕事中と休日のメリハリをつけて過ごしています。
Q9. 就職活動中の学生の方にメッセージをお願いします。
就職活動に加え、国家試験の勉強もあり本当に大変だと思いますが、
最後まで諦めずに頑張ってください。
最後まで諦めずに頑張ってください。
健診検査課 臨床検査技師(2024年入職)

Q1. 聖隷沼津病院・健診センターに入職の動機・きっかけ・決め手は?
地元に近く、お世話になった病院に貢献したいと考えたからです。
Q2. 職場の雰囲気を教えてください。
質問に丁寧に答えてもらえたり、不安な部分をしっかりサポートしてもらえる職場です。
Q3. あなたのお仕事内容を教えてください。
心電図、肺活量、採血を中心に業務を行っています。
また、眼底検査、超音波検査などの独り立ちに向けて頑張っています。
また、眼底検査、超音波検査などの独り立ちに向けて頑張っています。
Q4. やりがいを感じる瞬間は?
受診者さんから感謝の言葉をもらった時や、先輩方から褒められた時です。
Q5. 休暇は取れていますか?取りやすい環境ですか?
休暇を取りたいときに取れています。
Q6. 研究や自己研鑽は何かしていますか?また職場の協力体制はありますか?
病院や健診センターにある専門書を読んで、少しでも知識を増やそうとしています。
先輩からおすすめの本を教えてもらったりしています。
先輩からおすすめの本を教えてもらったりしています。
Q7. 教育体制はどうですか?充実していますか?
細かく段階を踏みながら出来る事を増やしていくため、自信が付きやすく、
どこで躓いているかが分かりやすい教育体制となっています。
どこで躓いているかが分かりやすい教育体制となっています。
Q8. 就職活動中の学生の方にメッセージをお願いします。
国家試験勉強と就職活動で大変な時期ですが、
息抜きもしつつメリハリをつけて頑張ってください。
息抜きもしつつメリハリをつけて頑張ってください。
利用者様へ
外来採血室のご案内
| 外来採血室 | |
|---|---|
| 場所 | 内科待合い前の13番 |
| 時間 | 8時15分から開始します |
I. 受付
予約採血・採尿の指示が出ている患者様へ
- 総合受付または再来機を通り、「基本スケジュール票」を持って外来採血室(13番)までお越しください。
- 朝は大変混雑します。採血や各種検査(検体提出等)がある方は、混雑防止のため「黄色の番号札」を取って(容器の下部から札を引き出す)お待ちください。
8時15分から「黄色の番号札」順にお呼びします。

診察後に採血・採尿の指示が出た患者様へ
「基本スケジュール票」を持って、外来採血室(13番)までお越しください。
※注意:採尿がない方にも、「排尿せずにお越し下さい。」と記載されます。
※注意:採尿がない方にも、「排尿せずにお越し下さい。」と記載されます。
Ⅱ.採血受付後
- 採血がある方は「整理番号券」を、尿検査がある方は「尿コップ」をお渡しします。
- モニターにて整理番号が表示されます。「基本スケジュール票」と「整理番号券」を持って、該当する採血ブースへお入りください。
- 患者間違い防止のため、フルネームでの個人確認を行っています。ご協力お願いします。
以下に該当する患者様は、採血時にスタッフへお申し出ください。
- 採血をしたときに気分が悪くなったことがある方
- 消毒や絆創膏にアレルギーをお持ちの方
- 採血部位を医師に指示されている方
- 血液をサラサラにするお薬を飲んでいる方や止まりにくい方
検査項目のご案内
各種検査項目については以下に掲載の項目案内をご覧ください。
項目案内は、総合受付後方のラックにパンフレット形式でもご用意しておりますので、ご自由にお持ちください。

